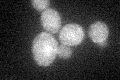
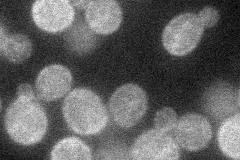
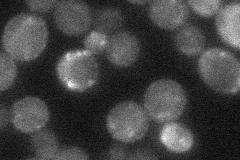
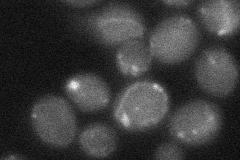
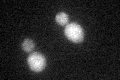

View description
Putative transporter in the major facilitator superfamily (DHA1 family) of multidrug resistance transporters; mutations in membrane-spanning domains permit cation and histidinol uptake
Localization:
Intensity:
Fold change:
Significance:
-
C’ GFP library in SD
cell periphery25.6 -
N' NOP1pr-GFP in SD
cell periphery30.8523 -
N' TEF2pr-mCherry in SD

cell periphery,vacuole179.194 -
N' NATIVEpr-GFP in SD
below threshold23.6189 -
N' TEF2pr-VC and Cyto-VN in SD
below threshold24.0516 -
C’ GFP library in SD+DTT
cell periphery19.060.74Yes -
C’ GFP library in SD+H2O2

cell periphery20.530.8No -
C’ GFP library in Starvation Media

cell periphery21.290.83No -
C’ GFP library on the background of Pup2-DaMP

cell periphery -
C’ GFP library on the background of CCT mutant

cell periphery22.59140.88206No
